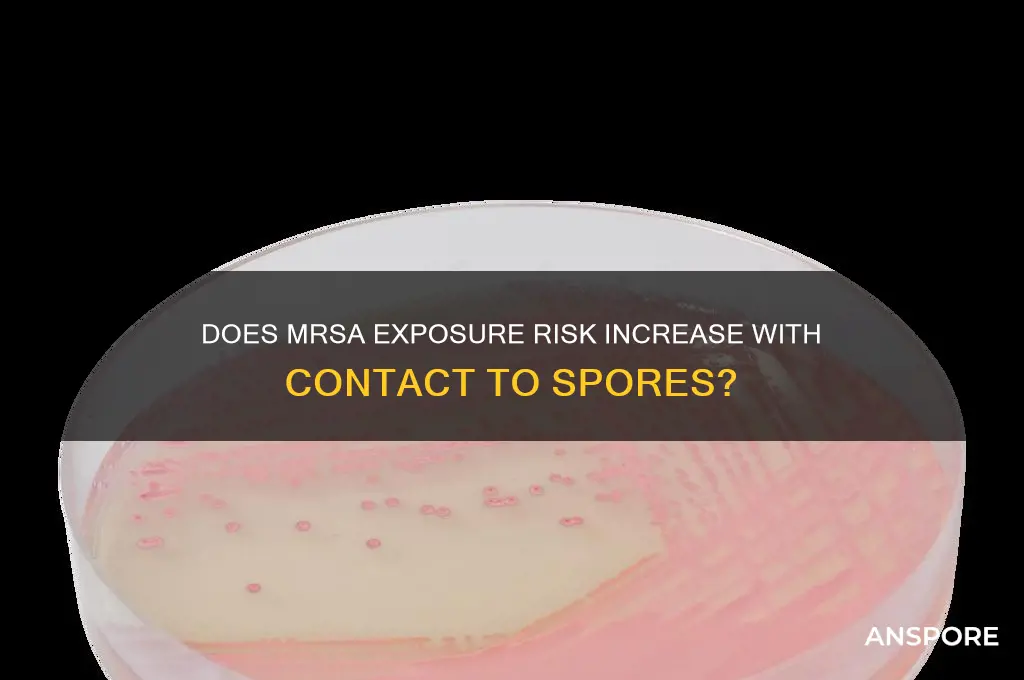
does mrsa make patient in contact with spores

Methicillin-resistant *Staphylococcus aureus* (MRSA) is a significant public health concern due to its resistance to many antibiotics, making it challenging to treat infections caused by this bacterium. While MRSA is primarily transmitted through direct contact with an infected person or contaminated surfaces, there is often confusion regarding its relationship with spores. Unlike spore-forming bacteria such as *Clostridioides difficile*, MRSA does not produce spores. Spores are highly resistant, dormant structures that allow certain bacteria to survive harsh conditions, but MRSA relies on its ability to colonize and persist in human hosts or environments without forming spores. Therefore, patients in contact with spores are not at risk of acquiring MRSA from spores themselves, though they may still be exposed to MRSA through other common transmission routes. Understanding this distinction is crucial for implementing appropriate infection control measures and addressing misconceptions about MRSA transmission.
| Characteristics | Values |
|---|---|
| Does MRSA produce spores? | No, MRSA (Methicillin-Resistant Staphylococcus aureus) is a non-spore-forming bacterium. It reproduces through binary fission and does not form spores as a survival mechanism. |
| Transmission via spores | Since MRSA does not produce spores, it is not transmitted via spores. Transmission occurs primarily through direct contact with an infected person or contaminated surfaces. |
| Survival outside the body | MRSA can survive on surfaces for varying durations (hours to days) depending on environmental conditions, but this is not due to spore formation. Survival is in its vegetative form. |
| Infection risk for patients in contact with spores | Not applicable, as MRSA does not produce spores. However, patients in contact with MRSA-contaminated surfaces or individuals are at risk of infection. |
| Prevention measures | Hand hygiene, proper disinfection of surfaces, and isolation precautions are key to preventing MRSA transmission, not spore-specific measures. |
| Relevance to spore-forming bacteria | MRSA is distinct from spore-forming bacteria like Clostridioides difficile, which require different infection control strategies due to spore persistence. |
Explore related products
What You'll Learn
- MRSA Transmission Risks: How MRSA spreads via contact with spores in healthcare settings
- Spores vs. MRSA: Differentiating between spore-forming bacteria and MRSA’s non-spore nature
- Patient Isolation Protocols: Preventing MRSA transmission through spore-related contact precautions
- Environmental Contamination: Role of surfaces in MRSA spread via spore-like persistence
- Treatment Challenges: Managing MRSA infections in patients exposed to spore-contaminated environments

MRSA Transmission Risks: How MRSA spreads via contact with spores in healthcare settings
Methicillin-resistant *Staphylococcus aureus* (MRSA) is a formidable pathogen, notorious for its resistance to multiple antibiotics. While direct contact with infected individuals or contaminated surfaces is a well-known transmission route, the role of spores in MRSA spread is less understood. Unlike spore-forming bacteria such as *Clostridioides difficile*, *S. aureus* does not produce spores. However, MRSA can survive in a dormant, resilient state on surfaces for weeks, mimicking spore-like persistence. This raises critical questions about how healthcare settings inadvertently facilitate transmission through contact with these resilient bacterial reservoirs.
In healthcare environments, MRSA’s ability to persist on surfaces like bed rails, doorknobs, and medical equipment creates a silent transmission risk. Unlike spores, which are highly resistant structures, MRSA’s survival relies on its ability to withstand desiccation and harsh conditions. For instance, a study in *Infection Control & Hospital Epidemiology* found that MRSA can remain viable on dry surfaces for up to 7 months. This persistence transforms everyday objects into potential vectors, particularly in high-traffic areas. Healthcare workers and patients who touch these surfaces can unknowingly transfer the bacteria, even if the initial contamination occurred days earlier.
The risk is compounded by the lack of visible indicators of contamination. Unlike spore-forming pathogens, which may leave residue or biofilms, MRSA’s presence is undetectable without testing. This invisibility necessitates stringent disinfection protocols, such as using EPA-approved disinfectants with proven efficacy against *S. aureus*. However, compliance remains a challenge. A survey in *The Journal of Hospital Infection* revealed that only 40% of healthcare facilities consistently follow disinfection guidelines, leaving gaps in infection control.
To mitigate transmission, healthcare settings must adopt a multi-pronged approach. First, frequent hand hygiene with alcohol-based sanitizers (minimum 60% alcohol content) is non-negotiable. Second, high-touch surfaces should be disinfected daily, or more frequently in isolation rooms. Third, education is key: staff and patients must understand the risks of surface contact and the importance of reporting symptoms promptly. For example, a patient with a history of MRSA colonization should be placed in contact precautions, with dedicated equipment to prevent cross-contamination.
While MRSA does not produce spores, its spore-like resilience on surfaces demands a spore-level response in healthcare settings. By treating contaminated surfaces with the same caution as spore-forming pathogens, facilities can significantly reduce transmission risks. This proactive approach not only protects patients but also preserves the efficacy of remaining antibiotics in an era of rising resistance.
Are Bacterial Spores Resistant to Antibiotics? Unraveling the Mystery
You may want to see also

Spores vs. MRSA: Differentiating between spore-forming bacteria and MRSA’s non-spore nature
MRSA, or Methicillin-Resistant Staphylococcus aureus, is a notorious pathogen known for its resistance to multiple antibiotics. Unlike spore-forming bacteria such as *Clostridioides difficile* or *Bacillus anthracis*, MRSA does not produce spores. This fundamental difference in biology has significant implications for transmission, treatment, and infection control. Spores are highly resilient structures that allow bacteria to survive extreme conditions, including heat, radiation, and disinfectants. MRSA, however, relies on its ability to colonize and infect living tissues directly, without the need for a dormant, protective form. Understanding this distinction is crucial for healthcare providers and patients alike, as it shapes how we prevent and manage infections caused by these organisms.
From a practical standpoint, the non-spore-forming nature of MRSA means that standard disinfection protocols are generally effective against it. Alcohol-based hand sanitizers, for example, can kill MRSA on surfaces and skin within seconds, provided they are used correctly. In contrast, spore-forming bacteria like *C. difficile* require specialized disinfectants, such as bleach solutions (1:10 dilution of 5.25% sodium hypochlorite), to ensure eradication. For patients in healthcare settings, this distinction is vital: MRSA precautions focus on contact isolation and hand hygiene, while *C. difficile* outbreaks demand terminal cleaning with sporicidal agents. Knowing whether you’re dealing with a spore-forming bacterium or MRSA can prevent unnecessary measures or ensure adequate protection.
The transmission dynamics of MRSA and spore-forming bacteria also differ markedly. MRSA spreads primarily through direct contact with colonized individuals or contaminated surfaces, making it a concern in crowded environments like hospitals and gyms. Spores, however, can persist in the environment for months or even years, posing a risk of indirect transmission long after the infected individual has left the area. For instance, a patient with a *C. difficile* infection may shed spores in their stool, which can contaminate surfaces and equipment, leading to new infections if not properly cleaned. MRSA, by contrast, does not leave behind such long-lasting environmental reservoirs, making its control more straightforward in theory, though still challenging in practice.
Clinically, the non-spore-forming nature of MRSA influences treatment strategies. Since MRSA is an active, replicating bacterium, antibiotics (when necessary) target its metabolic processes. Drugs like vancomycin or daptomycin disrupt cell wall synthesis or membrane integrity, effectively killing the organism. Spore-forming bacteria, however, require a two-pronged approach: spores must first be activated (or germinated) before antibiotics can act. This is why *C. difficile* infections are often treated with antibiotics like vancomycin or fidaxomicin, which target the vegetative form, but only after spores have germinated in the gut. Understanding this difference ensures that patients receive appropriate therapy, minimizing the risk of treatment failure or recurrence.
In summary, differentiating between spore-forming bacteria and MRSA’s non-spore nature is essential for effective infection control and treatment. While MRSA relies on active colonization and is susceptible to standard disinfection methods, spore-forming bacteria pose a unique challenge due to their environmental persistence and resistance. For patients, this means that MRSA precautions focus on immediate contact prevention, while spore-forming bacteria require more rigorous, long-term environmental management. By recognizing these distinctions, healthcare providers can tailor their strategies to combat these pathogens more effectively, ultimately improving patient outcomes and reducing the spread of infection.
Are Spores Reproducing Bacteria? Unraveling the Microbial Mystery
You may want to see also

Patient Isolation Protocols: Preventing MRSA transmission through spore-related contact precautions
MRSA, or Methicillin-Resistant Staphylococcus Aureus, is a bacterial infection notorious for its resistance to many antibiotics. While MRSA is primarily transmitted through direct contact with infected individuals or contaminated surfaces, the role of spores in its spread is often misunderstood. Unlike spore-forming bacteria such as Clostridioides difficile, MRSA does not produce spores. However, patient isolation protocols must still address spore-related contact precautions to prevent cross-contamination with other spore-forming pathogens that may coexist in healthcare settings.
In healthcare facilities, spore-forming bacteria like C. difficile can survive on surfaces for weeks, posing a significant risk to patients already vulnerable to infections like MRSA. To mitigate this, isolation protocols must incorporate stringent environmental cleaning measures. Surfaces in patient rooms, including bedrails, doorknobs, and medical equipment, should be disinfected with spore-killing agents such as chlorine-based solutions (e.g., 1,000–5,000 ppm hypochlorite). This ensures that even if MRSA is present, the environment is not concurrently harboring spore-forming pathogens that could exacerbate infection risks.
Healthcare workers play a critical role in preventing transmission. Adherence to contact precautions, such as wearing gloves and gowns when entering the room of a MRSA-positive patient, is non-negotiable. However, these precautions must be extended to include awareness of spore-forming pathogens. For instance, if a patient has both MRSA and C. difficile, healthcare workers should use additional protective measures, such as dedicated equipment and enhanced hand hygiene with alcohol-based rubs followed by soap and water to remove spores. This layered approach minimizes the risk of cross-contamination.
Patient education is another vital component of isolation protocols. Patients and their families should be informed about the importance of hand hygiene and the risks associated with spore-forming pathogens. For example, visitors should be instructed to perform hand hygiene before and after entering the patient’s room, using alcohol-based hand rubs for routine cleaning and soap and water if C. difficile is a concern. Clear, concise instructions tailored to the patient’s age and cognitive level can significantly improve compliance and reduce transmission risks.
Finally, monitoring and auditing isolation protocols are essential to ensure their effectiveness. Regular assessments of environmental cleaning practices, staff compliance with contact precautions, and patient outcomes can identify gaps in the system. For instance, if a cluster of MRSA and C. difficile cases emerges, it may indicate inadequate spore-killing disinfection practices or lapses in staff adherence to protocols. Addressing these issues promptly through targeted training and protocol adjustments can prevent further transmission and protect vulnerable patients.
Can C. Diff Spores Be Eliminated Permanently? Expert Insights Revealed
You may want to see also
Explore related products

Environmental Contamination: Role of surfaces in MRSA spread via spore-like persistence
Methicillin-resistant *Staphylococcus aureus* (MRSA) is notorious for its resilience, but its ability to persist in the environment like a spore is less understood. Unlike true spores, MRSA does not form a dormant, highly resistant structure. However, it can survive on surfaces for weeks, acting as a silent reservoir for transmission. This "spore-like persistence" is a critical factor in healthcare-associated infections (HAIs), where contaminated surfaces—bed rails, doorknobs, and medical equipment—become vectors for spread. Studies show MRSA can remain viable on dry surfaces for up to 7 months, though survival time varies with humidity, temperature, and surface type. Stainless steel and plastics, common in healthcare settings, support longer survival compared to fabrics or porous materials.
To mitigate this risk, targeted disinfection protocols are essential. Traditional cleaning agents like quaternary ammonium compounds may not suffice against MRSA biofilms, which enhance surface adherence and resistance. Instead, use EPA-registered disinfectants with proven efficacy against *S. aureus*, such as chlorine bleach (0.1% sodium hypochlorite) or hydrogen peroxide-based solutions. For high-touch surfaces, implement daily disinfection, especially in patient rooms and shared spaces. In outbreak scenarios, consider terminal cleaning with UV-C light or vaporized hydrogen peroxide to reduce environmental contamination.
A comparative analysis of surface materials reveals opportunities for infection control. Copper alloys, for instance, exhibit inherent antimicrobial properties, reducing MRSA viability within hours. Replacing high-touch components like door handles or tray tables with copper alternatives could passively decrease transmission. Similarly, antimicrobial coatings on medical devices and furniture provide a barrier to colonization. However, these measures are not standalone solutions; they must complement rigorous hand hygiene and personal protective equipment (PPE) use among healthcare workers.
Practical tips for patients and caregivers include using alcohol-based hand sanitizers (minimum 60% ethanol) before and after touching shared surfaces. Patients with MRSA should have dedicated equipment when possible, and linens should be laundered at ≥60°C with bleach. For home environments, focus on frequently touched areas like light switches, remote controls, and countertops. Educating patients on the importance of environmental hygiene is key, as many are unaware of MRSA’s surface persistence. By addressing this spore-like behavior, healthcare systems can disrupt transmission chains and protect vulnerable populations.
Where to Buy Moss Spores: A Comprehensive Guide for Enthusiasts
You may want to see also

Treatment Challenges: Managing MRSA infections in patients exposed to spore-contaminated environments
MRSA, or Methicillin-Resistant Staphylococcus Aureus, poses significant treatment challenges, particularly in patients exposed to spore-contaminated environments. Unlike MRSA itself, which does not form spores, certain bacteria like Clostridioides difficile (C. diff) produce spores that can persist in environments for extended periods. When patients with MRSA infections are also exposed to such spores, the risk of co-infection or treatment interference increases, complicating clinical management. This dual exposure demands a nuanced approach to treatment, balancing the eradication of MRSA while mitigating the risks associated with spore-forming pathogens.
One of the primary challenges is the potential for spore-forming bacteria to exacerbate skin and soft tissue infections caused by MRSA. For instance, patients in healthcare settings or long-term care facilities may encounter spore-contaminated surfaces, increasing the likelihood of wound colonization. Treatment protocols for MRSA, such as topical mupirocin (2% ointment applied thrice daily for 5–10 days) or oral antibiotics like clindamycin (300–450 mg every 6–8 hours), may be less effective if spores are present. Spores can survive standard disinfection methods, necessitating the use of sporicidal agents like bleach (1:10 dilution) for environmental decontamination. Clinicians must also consider the possibility of C. diff co-infection, which can manifest as severe diarrhea, particularly in patients on prolonged antibiotic therapy.
Instructively, managing these patients requires a multi-faceted strategy. First, isolate the patient to prevent cross-contamination, especially in healthcare settings. Second, implement strict hand hygiene protocols using alcohol-based hand rubs (at least 60% alcohol) or soap and water for visible soiling. Third, tailor antibiotic therapy to the patient’s condition, avoiding broad-spectrum agents that disrupt gut flora and increase spore germination risk. For example, reserve vancomycin (15–20 mg/kg every 8–12 hours) for severe MRSA infections, and consider alternatives like linezolid (600 mg every 12 hours) for patients at high risk of C. diff.
Persuasively, the importance of environmental control cannot be overstated. Spores can survive on surfaces for months, making routine cleaning inadequate. Facilities must adopt sporicidal disinfection protocols, particularly in high-risk areas like wound care units. Additionally, patient education is critical. Teach individuals to avoid touching contaminated surfaces and to promptly report symptoms like worsening skin lesions or gastrointestinal distress. For pediatric or elderly patients, caregivers should be trained in these measures to ensure compliance.
Comparatively, while MRSA and spore-forming bacteria differ biologically, their coexistence in a patient complicates treatment more than either pathogen alone. MRSA’s antibiotic resistance requires targeted therapy, while spores demand environmental vigilance. This dual burden underscores the need for integrated infection control strategies. For example, a patient with a MRSA wound infection in a spore-contaminated environment may require both systemic antibiotics and topical antiseptics like chlorhexidine gluconate (4% solution), alongside sporicidal environmental cleaning.
In conclusion, managing MRSA infections in spore-contaminated environments demands a comprehensive approach that addresses both the pathogen and its surroundings. By combining targeted antibiotic therapy, stringent infection control measures, and patient education, clinicians can improve outcomes and reduce the risk of complications. Practical steps, such as using sporicidal agents and avoiding broad-spectrum antibiotics, are essential to navigate this complex treatment landscape effectively.
Where to Legally Purchase Psilocybin Spores: A Comprehensive Guide
You may want to see also
Frequently asked questions
No, MRSA (Methicillin-resistant Staphylococcus aureus) does not produce spores. It is a bacterial infection that spreads through direct contact with an infected person or contaminated surfaces, not through spores.
Yes, patients with MRSA can come into contact with spores from other organisms, such as Clostridioides difficile (C. diff), but these spores are unrelated to MRSA and do not affect its transmission or infection.
No, exposure to spores from other organisms does not increase the risk of MRSA infection. MRSA spreads through direct contact, not through spore exposure.
No, MRSA cannot transform into a spore-forming bacteria. It remains a non-spore-forming bacterium, and its transmission is not related to spore production.

























